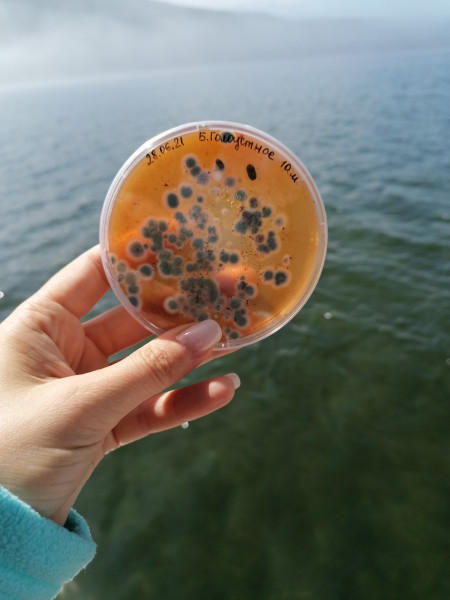
Fig_7

Expedition on board of R/V “Papanin” from June 28 till July 5, 2021
From June 28 till July 5, 2021 an expedition on board of R/V “Papanin” was performed covering the whole Lake Baikal within the State Assignment 0279-2021-0010 “Genetics of communities of Baikal organisms: gene pool structure, conservation strategies” (Leader Dr. D. Yu. Shcherbakov).
The aim of the expedition was to sample Baikal water life (amphipods, mollusks, metazoan green algae) for further morphometric, genetic and physiological studies. The ground was inoculated under expedition conditions onto selective media for further studies of species diversity of fungi and of their biochemical properties.
Sampling was performed using scrapers and dip nets at water edge, using a hydrobiological dredge and Petersen grab (S=0.025 m2) from the depths from 10 to 300 meters. For microbial studies, totally 18 near-shore samples of zoo- and phytobenthos, and 18 ground samples were collected.